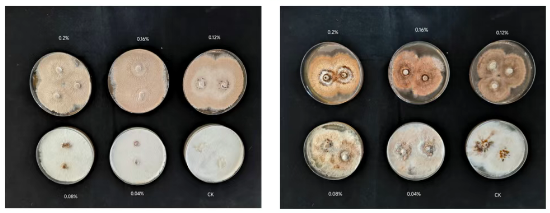

国家食用菌产业技术体系黑木耳品种改良岗位科学家、吉林农业大学园艺学院姚方杰教授团队开展黑木耳种质耐盐性评价筛选出耐盐菌株H2、盐敏感菌株H26,结合生理学与转录组学分析,首次系统揭示了黑木耳抵御盐胁迫机制,为黑木耳产业利用盐碱地、减少农田占用提供科学依据。

研究主要结论为黑木耳耐盐菌株H2在盐碱胁迫条件下表现出显著强于盐敏感菌株H26的耐受能力,在菌丝和子实体两个生长发育阶段,H2均能够维持更高的渗透调节能力、更强的抗氧化防御体系以及更低的细胞膜损伤水平。转录组分析揭示,参与GDP-甘露糖生物合成的关键酶基因g2692(编码甘露糖-6-磷酸异构酶,PMI)和g2546(编码 GDP-甘露糖焦磷酸化酶,GMPP)显著上调。实时荧光定量PCR分析表明,在盐胁迫条件下,H2菌株中调控GDP-甘露糖生物合成途径基因的表达水平显著高于H26,并伴随着细胞内甘露糖含量的显著增加,在黑木耳耐盐性形成过程中发挥了关键作用。本研究为提高黑木耳等食用菌在盐碱环境下的适应性提供了生理和分子水平的理论依据,为抗逆育种和利用盐渍植物残体作为替代栽培基质提供理论支持。
研究成果以题为“Transcriptomics-based study on the GDP-mannose synthesis pathway and salt tolerance mechanism in Auricularia heimuer”发表在国际学术期刊Scientia Horticulturae。
论文链接:https://doi.org/10.1016/j.scienta.2026.114647
图1 不同碳酸氢钠浓度下H2(A)和H26(B)菌株的菌丝形态

图2 耐盐菌株H2(R)与盐敏感菌株H26(S)在不同碳酸氢钠浓度下的生理指标变化(p<0.05)

图3 (A)样本间基因表达水平相关性热图,(B)差异表达基因统计分析,(C)差异表达基因聚类分析













